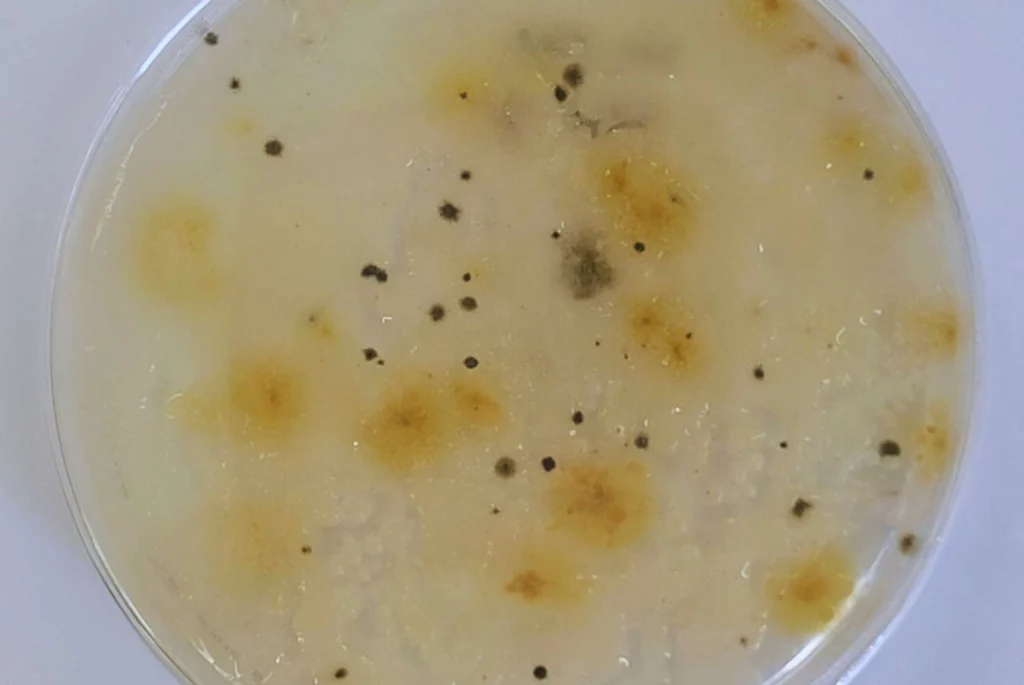

La pilosela no es una maleza nueva en el sur argentino y chileno. A esta vieja conocida se la sabe muy agresiva contra los pastizales naturales y de rápida expansión. Por eso, ante la falta de pautas de manejo adecuadas y métodos de control efectivos, esta especie invasora se ha convertido en una de las principales amenazas para la ganadería de esas regiones.
Esta planta, que es reconocible por sus flores amarillas y por conformar grandes mantos sobre otras gramíneas, lo que hace es afectar la diversidad vegetal y “competir” por los recursos con estas. La consecuencia directa es que, para una región que de por sí carece de materia verde en abundancia, haya mucho menos alimento disponible para la fauna local y los animales de cría y engorde.
Eso fue lo que suscitó la búsqueda de una solución más efectiva y con menos impacto al uso de herbicidas, en la que hoy trabaja un equipo conformado por el INTA y el CADIC-Conicet en conjunto con el gobierno de Tierra del Fuego.

La idea que motoriza al proyecto es la búsqueda de microorganismos nativos del suelo que puedan tener un efecto antagonista sobre la especie invasora, de origen euroasiático pero ya muy anclada en la región. De ese modo, los investigadores confían en que pueden recuperarse los pastizales naturales reduciendo el uso de herbicidas y aportando sustentabilidad de la ganadería en la isla.
El proyecto fue presentado por la Secretaría de Desarrollo Productivo y PyME del gobierno provincial y es financiado por el Consejo Federal de Inversiones (CFI). Durante esta primera etapa, ya se recolectaron muestras de suelo, aislamiento de bacterias, hongos y cianobacterias, y se evaluó su capacidad para inhibir la germinación o el crecimiento de la planta.
Además de su rápido crecimiento in situ, la pilosela puede llegar a nuevos ambientes muy rápidamente gracias a la propagación de semillas con el viento. Eso la hace mucho más efectiva y amenazante ante la actividad productiva de la zona más austral del país, en donde ven con preocupación cómo disminuye la cantidad y calidad de alimento disponible tanto para el ganado doméstico como para la fauna nativa.
Justamente, Tierra del Fuego es una provincia que, por sus condiciones naturales y la falta de producción propia de granos, depende en gran medida de la salud de los pastizales naturales para producir carne.
“Actualmente se observa esta hierba en parches que pueden alcanzar entre un 10% y un 70% de cobertura en algunos potreros, encontrándose presente en toda la isla, con mayor predominancia en la ecorregión de estepa magallánica y en menor medida en ecotono”, explicó Macarena Cardozo, becaria de la Agencia de Extensión Rural Río Grande del INTA e integrante del proyecto de investigación.
La búsqueda de microorganismos nativos con potencial antagonista responde a la necesidad de complementar otras estrategias de combate de esta maleza en la región, en lo que se espera que a futuro sea un manejo integrado mucho más “pulido”.
Hasta ahora, como no hay un trabajo de detección temprana ni de control sobre focos incipientes, algunos establecimientos agropecuarios han optado por el control químico mediante pulverizaciones terrestres en grandes extensiones.
Pero, si bien ha demostrado ser efectivo, el uso de herbicidas tiene como contracara el aumento de gastos en maquinaria y mano de obra -que no abunda en la región-, y a la vez la necesidad de contar con condiciones climáticas muy específicas. Cabe agregar que, como no hay un plan específico para hacerlo, es una estrategia que implementan pocos productores de forma aislada.
“A estas dificultades se suma que la tasa de crecimiento anual de la pilosela ronda entre el 15 % y el 20 %, lo que implica que la superficie tratada cada año es reducida en comparación con la superficie ya invadida o en proceso de expansión”, observó Cardozo, que destacó la importancia de que, desde la investigación pública, se introduzcan nuevas prácticas para enfrentar de manera más sostenible la expansión de esta maleza.





